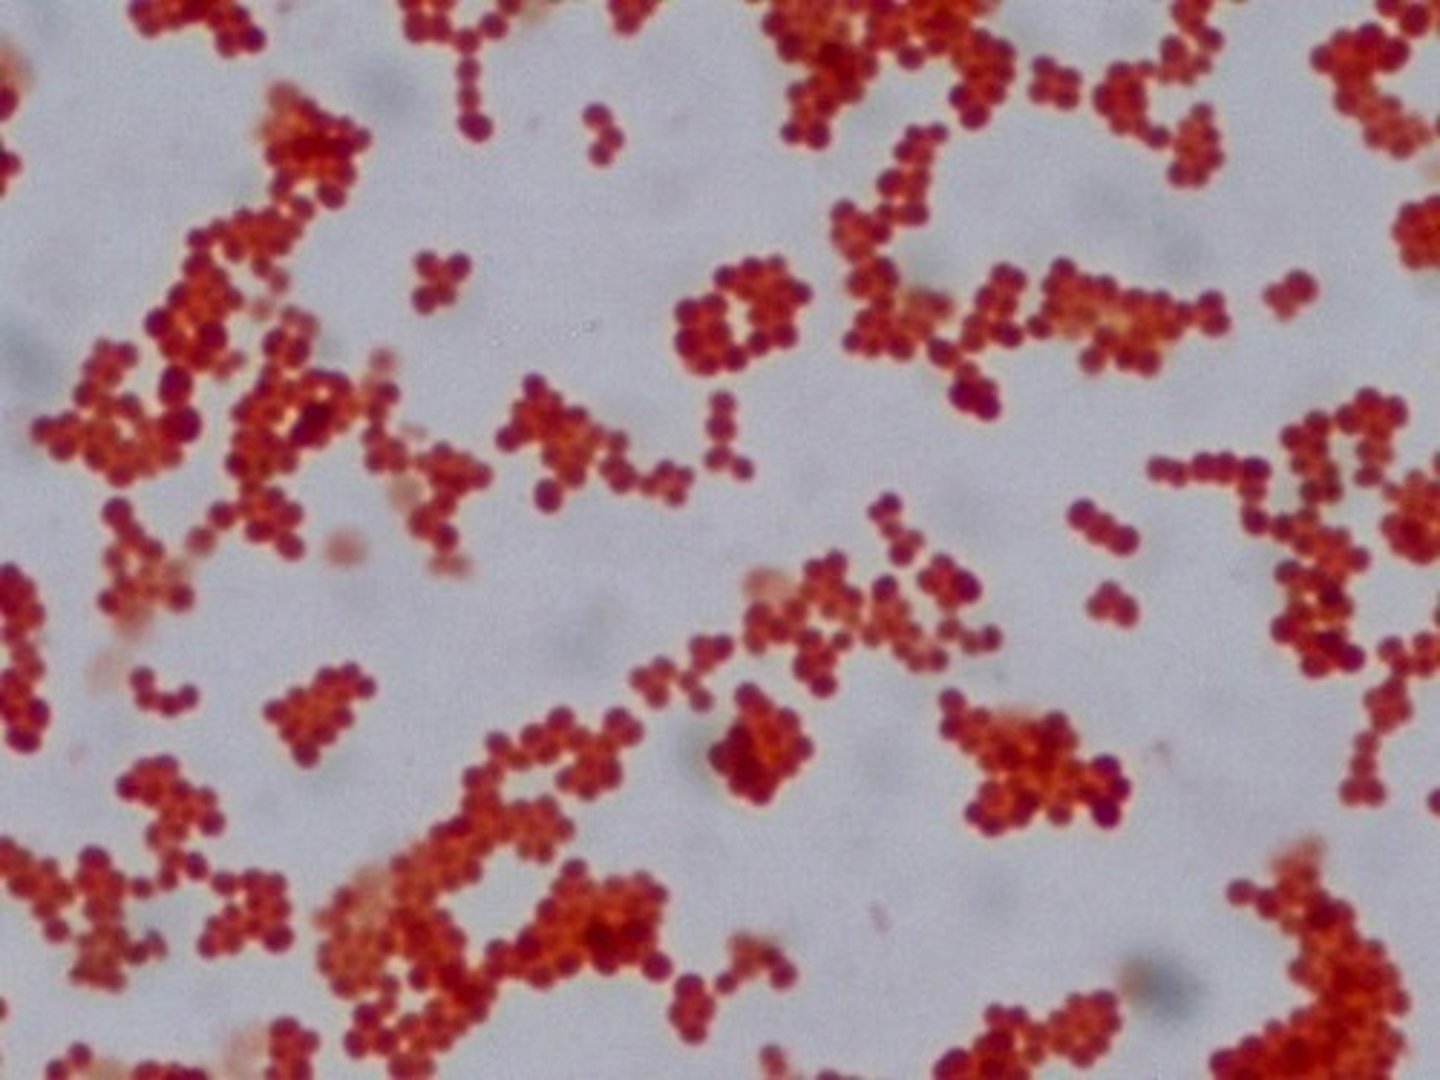
knowt flashcard image

1/49
Looks like no tags are added yet.
Name | Mastery | Learn | Test | Matching | Spaced |
|---|
No study sessions yet.
Direct Smear from Swab
rolling the swab across the slide to avoid destruction of cellular entities
Direct Smears from Concentrated Specimens
smears of concentrated centrifuged specimens by using a sterile, plastic transfer pipette
Smears from Cultures (subculture smears)
spreading a thin film of bacteria on the surface of a clean glass slide
Smears from Blood Culture Bottles
a preparation of a blood sample on a slide that can be examined under a microscope
Smears from Solid Media
the process of preparing a thin film of bacterial cells on a microscope slide by transferring a small sample of bacteria grown on a solid culture medium (like an agar plate) to a drop of sterile water on the slide, then spreading it evenly to create a suitable specimen for staining and microscopic examination
Inoculating Loop

Inoculating Needle

Simple Staining
The use of a single stain to color a bacterial organism is commonly referred to as?
methylene blue, basic fuchsin, and crystal violet
most commonly used dyes for simple staining are?
Hans Christian Gram
Danish bacteriologist who originally devised Gram Staining in 1882 (published 1884)
Gram Staining
It is almost always the first test performed for the identification of bacteria.
Crystal Violet
primary stain of the Gram's method is?
Methylene Blue
gram staining is sometimes substituted with?
Gram Positive
retain crystal violet-iodine complex; purple complex
Gram Negative
Others that are not stained by crystal violet that appear RED are
Gram Positive Cocci

Gram Negative Cocci
Gram Positive Bacilli

Gram Negative Bacilli

Cocci
generally round, oval or spherical shaped
Bacilli
rod shaped bacteria
Spirilla
spiral-shaped bacteria with a rigid structure
Yeast
may appear as single cells that may have buds. it also appears to be circular or ovoid larger than cocci
Single
a single bacterium
Diplo
pair of bacteria
Tetrad
a group of four bacteria arranged in a square
Sarcina
group of eight bacteria arranged in a cube
in Clusters
bacteria are arranged in clusters
in Chains
bacteria are arranged in chains
Coccus

Diplococci

Tetrad

Sarcina

Staphylococci

Streptococci

Bacillus

Diplobacilli

Streptobacilli

Vibrio

Pallisades

Coccobacilli

Spirochetes

Spirilla

๐๐ฐ๐ณ๐บ๐ฏ๐ฆ๐ฃ๐ข๐ค๐ต๐ฆ๐ณ๐ช๐ถ๐ฎ ๐ฅ๐ช๐ฑ๐ฉ๐ต๐ฉ๐ฆ๐ณ๐ช๐ข๐ฆ
Gram-positive pathogenic bacterium that causes diphtheria
๐๐ช๐ฃ๐ณ๐ช๐ฐ ๐ค๐ฉ๐ฐ๐ญ๐ฆ๐ณ๐ข๐ฆ
causative agent of cholera
๐๐ณ๐ฆ๐ฑ๐ฐ๐ฏ๐ฆ๐ฎ๐ข ๐ฑ๐ข๐ญ๐ญ๐ช๐ฅ๐ถ๐ฎ
causative agent of Syphillis
๐๐ฆ๐ญ๐ช๐ค๐ฐ๐ฃ๐ข๐ค๐ต๐ฆ๐ณ ๐ฑ๐บ๐ญ๐ฐ๐ณ๐ช
causative agent of bacterial ulcer
spiral organisms
all _______ are reported as gram negative
All COCCI are GRAM POSITIVE except:
๐๐ฆ๐ช๐ด๐ด๐ฆ๐ณ๐ช๐ข ๐ด๐ฑ๐ฑ.
๐๐ณ๐ข๐ฏ๐ฉ๐ข๐ฎ๐ฆ๐ญ๐ญ๐ข ๐ด๐ฑ๐ฑ.
๐๐ฆ๐ช๐ญ๐ญ๐ฐ๐ฏ๐ฆ๐ญ๐ญ๐ข ๐ด๐ฑ๐ฑ.
๐๐ฐ๐ณ๐ข๐น๐ฆ๐ญ๐ญ๐ข ๐ด๐ฑ๐ฑ.
All BACILLI are GRAM NEGATIVE except:
๐๐บ๐ค๐ฐ๐ฃ๐ข๐ค๐ต๐ฆ๐ณ๐ช๐ถ๐ฎ ๐ด๐ฑ๐ฑ.
๐๐ญ๐ฐ๐ด๐ต๐ณ๐ช๐ฅ๐ช๐ถ๐ฎ ๐ด๐ฑ๐ฑ.
๐๐ฐ๐ณ๐บ๐ฏ๐ฆ๐ฃ๐ข๐ค๐ต๐ฆ๐ณ๐ช๐ถ๐ฎ ๐ด๐ฑ๐ฑ.
๐๐ข๐ค๐ช๐ญ๐ญ๐ถ๐ด ๐ด๐ฑ๐ฑ.
๐๐ณ๐บ๐ด๐ช๐ฑ๐ฆ๐ญ๐ฐ๐ต๐ฉ๐ณ๐ช๐น ๐ด๐ฑ๐ฑ.
๐๐ช๐ด๐ต๐ฆ๐ณ๐ช๐ข ๐ด๐ฑ๐ฑ.
๐๐ข๐ค๐ต๐ฐ๐ฃ๐ข๐ค๐ช๐ญ๐ญ๐ถ๐ด ๐ด๐ฑ๐ฑ.